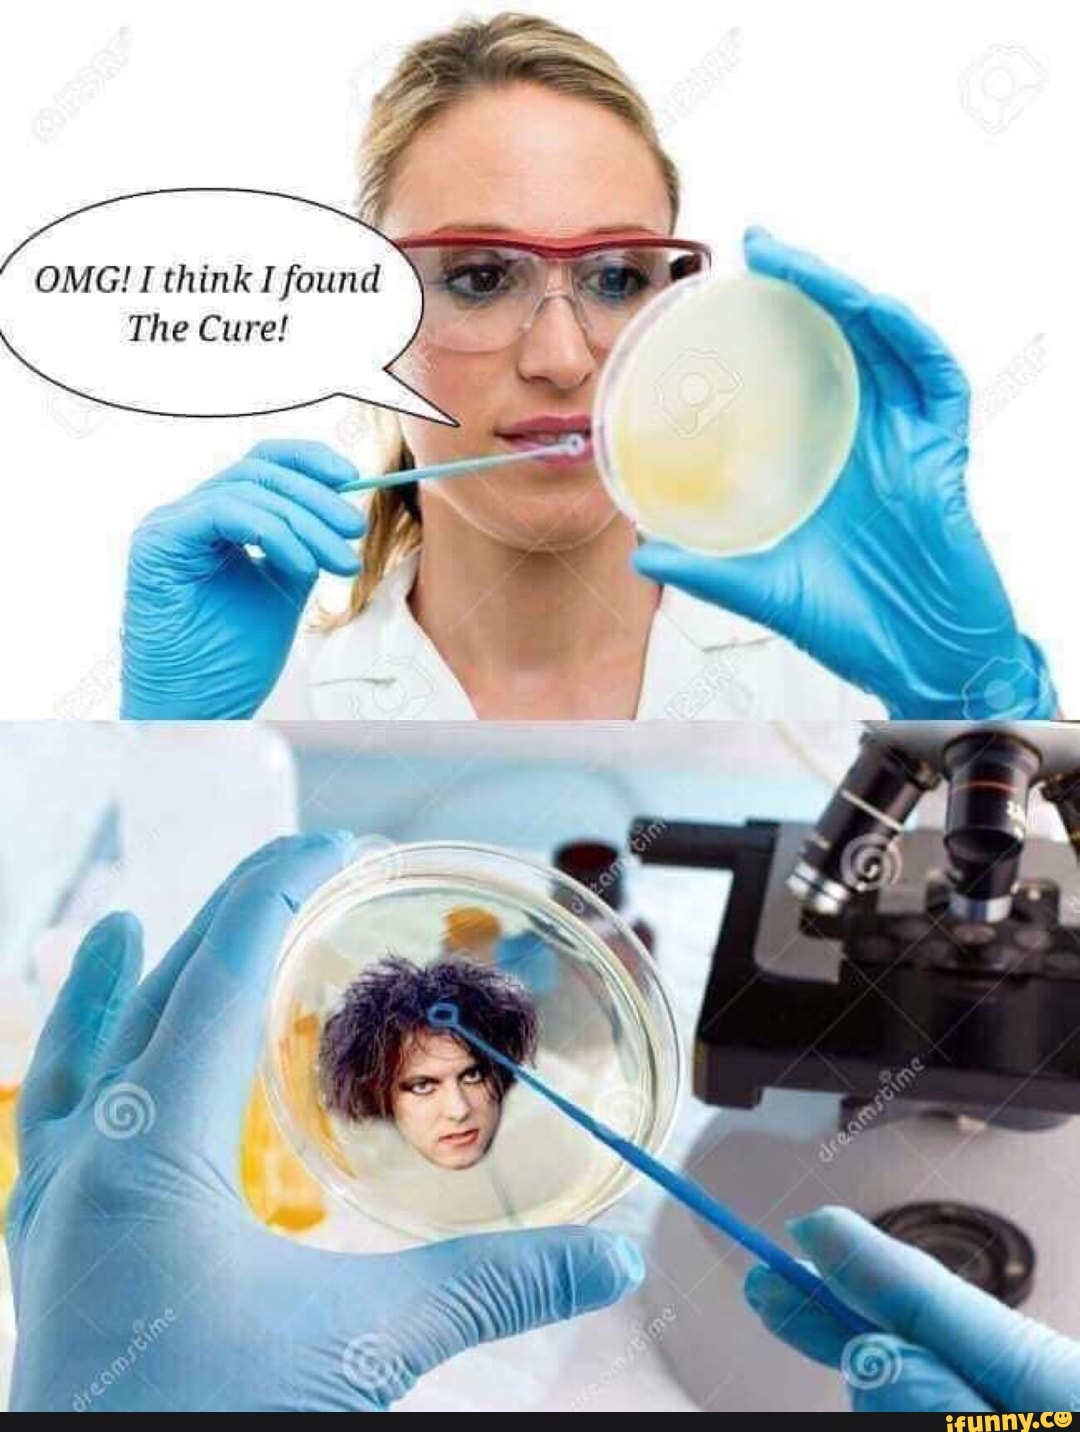

Think found
Babysitter Raped Porn
Hot Hentai Babes
Chat Webcam Sexo
Best friends mom riding free porn image
I Know U Crave It
NRI Gorgeous Babe Ruta
Sister Blackmail Anal
Au Pair Porn Films 2004
Teacher Punishment Porn Videos Samantha Rone Is A Kinky Slut Who Gets Her Asshole Punished Her Teacher Dana Vespoli
Youporn Xxx
EPantyhoseLand Video: Jenny
A cute beauty on the Balcony
Free Odd Porn
Think found 115 photos